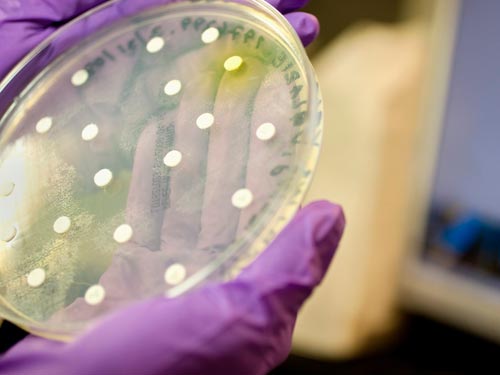

La microbiología para el diagnóstico veterinario involucra el reconocimiento de un gran número de microorganismos que pueden causar, o están directamente relacionadas con una enfermedad infecciosa en animales.
La contribución de un laboratorio de diagnóstico microbiológico recae en la identificación de una enfermedad infecciosa en animales y en la selección de la terapia quimioterapéutica necesaria, a su vez esta información está influenciada por varios factores, algunos relacionados a la especie y otros al laboratorio. Estos incluyen:
- El tipo y la calidad de la muestra recolectada.
- La etapa de la enfermedad en la que la muestra fue tomada.
- El cuidado con el que la muestra fue recolectada.
- La historia clínica que acompaña al caso.
Colección y envío de muestras para el diagnóstico:
- Las muestras deben ser tomadas de especímenes vivos o muertos recientemente.
- Las muestras ser tomadas del sitio afectado en consecuencia con los signos clínicos del animal.
- Las muestras deben colectarse de los bordes de la lesión e incluir algunos restos macroscópicos del tejido. Esto debido a que la replicación de los microorganismos patógenos en mayor en los bordes de las lesiones.
- Es importante que la colección de las muestras sea de la forma más aséptica posible, de no ser así, los patógenos relevantes pueden enmascararse por una alta cantidad de bacterias contaminantes.
- Las muestras deben siempre ser recolectadas antes de la administración de alguna forma de tratamiento.
- Las muestras enviadas sin algún tipo de medio de transporte tiene un alto riesgo de desecación lo que puede ocasionar que el patógeno relevante no pueda ser aislado en el laboratorio.
- Las muestras individuales deben ser enviadas por separado, correctamente identificadas y con la fecha de colección visible.
- Si el transporte al laboratorio es retrasado, las muestras deben ser refrigeradas a 4ºC. No deben ser congeladas.
- Para obtener un diagnóstico completo y certero, las pruebas de laboratorio de microbiología debe complementarse con pruebas de patología, serología, hematología, etc.
Tipos de Cultivo
A. Cultivos Bacterianos
Un cultivo de bacterias es necesario cuando se quiere determinar el agente etológico específico de alguna infección para una terapia antibiótica más efectiva. Es además el método diagnóstico de elección cuando la terapia antibiótica empírica no resuelve la infección y las bacterias se vuelven resistentes al quimioterapéutico previamente elegido.
Estos cultivos involucran dos etapas:
B. Cultivos de Hongos
Un cultivo de hongos está indicado para cuando se sospecha que el agente causal es un hongo como método de confirmación y para la elección de una terapia anti fúngica correcta para su tratamiento.
Estos cultivos involucran dos etapas: